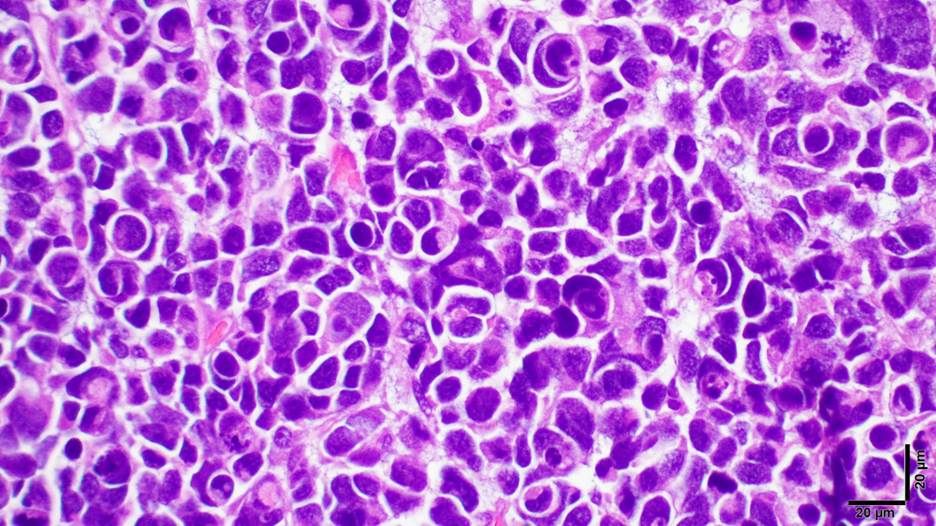
A photomicrograph of a large cell/anaplastic pediatric medulloblastoma

Rebecca Collins wins 2026 Enid Gilbert Barness Prize

Rebecca Collins, M.D., was awarded by the Society of Pediatric Pathology the prestigious 2026 Enid Gilbert Barness Prize, which recognizes the impact of an outstanding pediatric pathology paper on anatomic pathology, clinical practice, research, or public health, and encourages excellence and relevance in pediatric pathology practice.
Dr. Collins was conferred the award for her publication: Melanoma antigens in pediatric medulloblastoma contribute to tumor heterogeneity and species-specificity of group 3 tumors. This publication represents the culmination of collaborative multi-institutional and multi-year work investigating the proteomics of pediatric medulloblastomas.
In their work, Dr. Collins (the lead author) and her co-authors show, for the first time, that in an aggressive subset of pediatric medulloblastomas (group 3 medulloblastomas), there is characteristic expression of a family of proteins called Melanoma Antigen GEnes (MAGEs), a type of Cancer-Testis Antigen (CTA). Under normal circumstances, the expression of MAGE proteins is restricted to reproductive tissues especially testes, but their aberrant expression has been implicated in the carcinogenesis of many cancers. The work of Dr. Collins and her team illuminates not only the expression of Type I MAGEs in more than half of group 3 pediatric medulloblastomas, but also that targeted depletion of the expressed MAGE proteins leads to decreased proliferation and increased cell death of the medulloblastoma cells, thus creating future avenues for precision treatment of these aggressive pediatric cancers.
Congratulations Dr. Collins!
